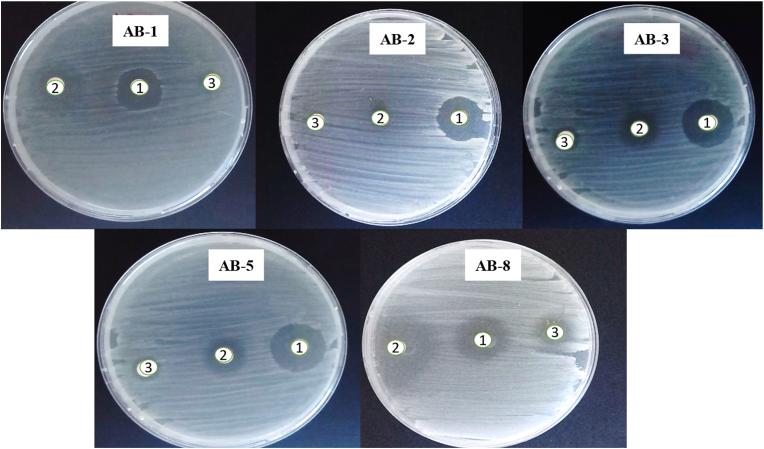
https://cdn.ncbi.nlm.nih.gov/pmc/blobs/c303/12345895/8e0042e5a0a8/gr2.jpg

使用生物合成的银纳米颗粒与亚胺培南联合应对耐碳青霉烯类鲍曼不动杆菌(CRAB)及其毒力因子。
Tackling carbapenem-resistant (CRAB) and their virulence factors using biosynthesized silver nanoparticles combined with imipenem.
作者信息
Shawky Mohamed, Kalaba Mohamed H, El-Sherbiny Gamal M
机构信息
Botany and Microbiology Department, Faculty of Science (Boys), Al-Azhar University, Cairo, 11884, Egypt.
出版信息
Biotechnol Notes. 2025 Jul 19;6:183-195. doi: 10.1016/j.biotno.2025.07.002. eCollection 2025.
Carbapenem-resistant is an extremely hazardous microorganism due to its high level of resistance to a wide array of antibiotics, making it a significant public health concern. Herein, this study aimed to biofabricate silver nanoparticles using a cell-free filter derived from sp., with a focus on characterizing their physicochemical properties, and use them to combat CRAB and their virulence factors. The biofabricated Ag-NPs were predominantly spherical with an average size 50 nm, confirmed through TEM analyses, while DLS measurements showed an average hydrodynamic diameter of approximately 36.78 nm. UV-Vis spectroscopy displayed a characteristic surface plasmon resonance peak in the range of 420 nm, indicative of nanoparticle formation. XRD confirmed the crystalline structure, presenting peaks corresponding to face-centered cubic silver. FTIR spectroscopy revealed active participation of metabolite compounds derived from the yces cell-free filter in both reduction and stabilization processes. Eight clinical bacterial isolates were identified as CRAB using the Vitek-2 system, and biofilm formation with 100 % was assessed through Congo red and microplate assays. The MIC for Ag-NPs and imipenem (IMP) were found to be between 4 and 5 μg/mL and 13 and 15 μg/mL, respectively. Additionally, the fractional inhibitory concentration index (FICI) for the synergistic combinations of Ag-NPs and IMP ranged from 0.5 to 0.375, indicating a notable decrease in the MIC values for both IMP and Ag-NPs from 14 and 5 μg/mL to 1.75 and 1.25 μg/mL, respectively. The qRT-PCR demonstrated a significant reduction in the expression levels of the and genes by up to 4.0-fold (p ≤ 0.001). The time-killing assay confirmed that the bacterial strain was effectively eliminated through the synergistic action of Ag-NPs and IMP. Moreover, the cytotoxicity assessment of Ag-NPs and their combination with IMP revealed low toxicity of the combination of Ag-NPs and IMP, with an IC of 26.13 ± 0.24 and 45.33 ± 0.21 μg/mL, respectively (p < 0.0019), indicating good biosafety, while the hemolysis rates were recorded at 0.4 and 0.7 at 12 and 24 h, respectively. We concluded that the combination of Ag-NPs with IMP could serve as a promising alternative strategy for treating CRAB.
耐碳青霉烯类是一种极其危险的微生物,因为它对多种抗生素具有高度抗性,这使其成为一个重大的公共卫生问题。在此,本研究旨在利用源自某菌的无细胞滤液生物合成银纳米颗粒,重点是表征其物理化学性质,并利用它们对抗耐碳青霉烯类鲍曼不动杆菌(CRAB)及其毒力因子。通过透射电子显微镜(TEM)分析证实,生物合成的银纳米颗粒(Ag-NPs)主要为球形,平均尺寸为50纳米,而动态光散射(DLS)测量显示平均流体动力学直径约为36.78纳米。紫外可见光谱在420纳米范围内显示出特征性的表面等离子体共振峰,表明纳米颗粒形成。X射线衍射(XRD)证实了晶体结构,呈现出与面心立方银相对应的峰。傅里叶变换红外光谱(FTIR)显示,源自该菌无细胞滤液的代谢物化合物在还原和稳定过程中都有积极参与。使用Vitek-2系统鉴定出8株临床细菌分离株为CRAB,并通过刚果红和微孔板试验评估了100%的生物膜形成情况。发现Ag-NPs和亚胺培南(IMP)的最低抑菌浓度(MIC)分别在4至5微克/毫升和13至15微克/毫升之间。此外,Ag-NPs与IMP协同组合的分数抑菌浓度指数(FICI)在0.5至0.375之间,表明IMP和Ag-NPs的MIC值均显著降低,分别从14和5微克/毫升降至1.75和1.25微克/毫升。定量逆转录聚合酶链反应(qRT-PCR)表明,某基因和某基因的表达水平显著降低,最高可达4.0倍(p≤0.001)。时间杀菌试验证实,通过Ag-NPs和IMP的协同作用,该细菌菌株被有效清除。此外,Ag-NPs及其与IMP组合的细胞毒性评估显示,Ag-NPs与IMP组合的毒性较低,IC50分别为26.13±0.24和45.33±0.21微克/毫升(p<0.0019),表明具有良好的生物安全性,而溶血率在12小时和24小时分别为0.4和0.7。我们得出结论,Ag-NPs与IMP的组合可作为治疗CRAB的一种有前景的替代策略。